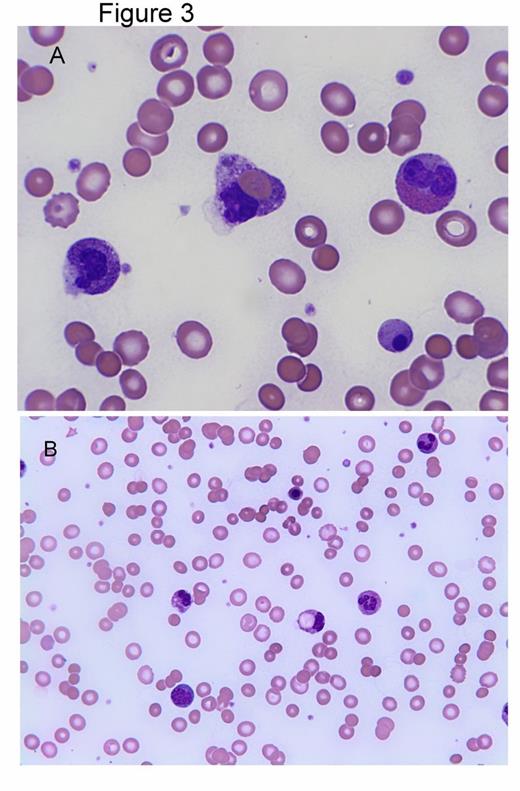
Figure 3:. Peripheral smear findings

Abstract
Introduction: Brown recluse spider bites are encountered commonly in endemic areas of North and South America. Loxosceles reclusa is the species of Loxosceles most commonly seen in the states of MO, KS, OK, TX, AK, LA, KY, TN, MS, AL and parts of IL, IA, IN and GA. The incidence of hemolytic anemia with systemic loxoscelism in the USA seems to be significantly higher and more severe than the incidence and severity reported in studies from South America (13%-15% incidence). In our 6 cases of loxoscelism associated with severe hemolysis, we noticed that there are signs and symptoms that could be helpful to guide the follow up and facilitate early diagnosis.
Method: We reviewed 6 cases of hemolytic anemia from Loxoscelism treated at the University of Missouri Hospitals. Of these 6 cases 4 were treated within 1 year. All of the cases presented with systemic and cutaneous manifestations. Each patient was initially treated symptomatically and discharged without a close follow up. This resulted in delayed presentations with symptoms of severe hemolytic anemia associated with significant morbidity [Syncope (1), Syncope with fracture (1), Hypotension needing ICU care (1), Necrotizing fasciitis (1), and severe hepatosplenomegaly with hyperbilirubinemia (1)]. We have summarized the systemic symptoms, peripheral blood smear and laboratory findings that correlate with hemolytic anemia.
Results:Patients presented with Nausea (6/6), Vomiting (5/6), Fever (5/6), and Target lesion (6/6) within 48 hours after spider bite [Table 1]. Severe hemolysis developed at a median of 6.5 days after the spider bite. DAT was positive for IgG and C3 in all of the cases. Peripheral smear findings included leukocytosis with toxic granulations, Dohle bodies and left shift, Nucleated RBC, anisopoikilocytosis with some schistocytes, hemophagocytosis and normal to decreased platelets [Figure 1] [Figure 3]. When not recognized patients presented with sudden and severe hemolysis (median drop in Hb =7.5 g/dL) [Table2] resulting in hospitalization with severe morbidity (Figure 2).
| . | Initial Presentation . | Significant Morbidity . |
|---|---|---|
| Patient 1 | Nausea and vomiting. Fever. Diffuse rash, RUQ pain Target lesion on back | Severe Jaundice Hepatomegaly Splenomegaly |
| Patient 2 | Nausea, vomiting and diarrhea. Fever Target lesion on left arm | Syncope Ankle fracture |
| Patient 3 | Nausea, fatigue and malaise. Target lesion on right back | Recurrent syncope |
| Patient 4 | Nausea, Vomiting Fever Target lesion right arm. | Severe Hypotension ICU care |
| Patient 5 | Nausea, dry heaves Fever. Thigh pain Target lesion right thigh. | Necrotizing fasciitis Fasciotomy |
| Patient 6 | Nausea, vomiting and fatigue. Fever. Target lesion right shoulder. |
| . | Initial Presentation . | Significant Morbidity . |
|---|---|---|
| Patient 1 | Nausea and vomiting. Fever. Diffuse rash, RUQ pain Target lesion on back | Severe Jaundice Hepatomegaly Splenomegaly |
| Patient 2 | Nausea, vomiting and diarrhea. Fever Target lesion on left arm | Syncope Ankle fracture |
| Patient 3 | Nausea, fatigue and malaise. Target lesion on right back | Recurrent syncope |
| Patient 4 | Nausea, Vomiting Fever Target lesion right arm. | Severe Hypotension ICU care |
| Patient 5 | Nausea, dry heaves Fever. Thigh pain Target lesion right thigh. | Necrotizing fasciitis Fasciotomy |
| Patient 6 | Nausea, vomiting and fatigue. Fever. Target lesion right shoulder. |
Peripheral Smear Findings of Systemic Loxoscelism
Significant Morbidity from Systemic Loxoscelism
Peripheral smear findings
| . | Patient 1 . | Patient 2 . | Patient 3 . | Patient 4 . | Patient 5 . | Patient 6 . | Median . |
|---|---|---|---|---|---|---|---|
| Age | 34 | 31 | 21 | 25 | 21 | 22 | 23.5 |
| Days after bite to lowest Hemoglobin | 8 | 5 | 6 | 6 | 7 | 9 | 6.5 |
| Baseline Hb (g/dL) | 11 | 12 | 15 | 13 | 13.8 | 15.7 | 13.4 |
| Lowest Hb (g/dL) | 5.7 | 4 | 5 | 6 | 6.6 | 8.4 | 5.85 |
| MCV with lowest Hb (fL) | 70 | 107 | 100 | 90 | 96.6 | 101 | 98.3 |
| WBC (103/µL) | 12.6 | 42 | 32.3 | 14.5 | 33.4 | 26.6 | 29.45 |
| Platelets (103/µL) | 160 | 141 | 234 | 64 | 261 | 576 | 197 |
| LDH (unit/L) | hemolysed | 2080 | 951 | 1348 | 744 | 346 | 951 |
| T. Bili (mg/dL) | 35.4 | 13.2 | 5 | 1.8 | 3.7 | 7.4 | |
| D. Bili (mg/dL) | >10 | 9.2 | .3 | .5 | 0.3 | 1.4 | |
| Ind. Bili (mg/dL) | 3.9 | 4.7 | |||||
| AST (unit/L) | 100 | 52 | 25 | 201 | 120 | 156 | |
| ALT (unit/L) | 86 | 95 | 19 | 91 | 104 | 294 | |
| Alk phos (unit/L) | 94 | 88 | 67 | 36 | 160 | 159 | |
| Blood group | A Pos | A Pos | O Pos | B Pos | O Pos |
| . | Patient 1 . | Patient 2 . | Patient 3 . | Patient 4 . | Patient 5 . | Patient 6 . | Median . |
|---|---|---|---|---|---|---|---|
| Age | 34 | 31 | 21 | 25 | 21 | 22 | 23.5 |
| Days after bite to lowest Hemoglobin | 8 | 5 | 6 | 6 | 7 | 9 | 6.5 |
| Baseline Hb (g/dL) | 11 | 12 | 15 | 13 | 13.8 | 15.7 | 13.4 |
| Lowest Hb (g/dL) | 5.7 | 4 | 5 | 6 | 6.6 | 8.4 | 5.85 |
| MCV with lowest Hb (fL) | 70 | 107 | 100 | 90 | 96.6 | 101 | 98.3 |
| WBC (103/µL) | 12.6 | 42 | 32.3 | 14.5 | 33.4 | 26.6 | 29.45 |
| Platelets (103/µL) | 160 | 141 | 234 | 64 | 261 | 576 | 197 |
| LDH (unit/L) | hemolysed | 2080 | 951 | 1348 | 744 | 346 | 951 |
| T. Bili (mg/dL) | 35.4 | 13.2 | 5 | 1.8 | 3.7 | 7.4 | |
| D. Bili (mg/dL) | >10 | 9.2 | .3 | .5 | 0.3 | 1.4 | |
| Ind. Bili (mg/dL) | 3.9 | 4.7 | |||||
| AST (unit/L) | 100 | 52 | 25 | 201 | 120 | 156 | |
| ALT (unit/L) | 86 | 95 | 19 | 91 | 104 | 294 | |
| Alk phos (unit/L) | 94 | 88 | 67 | 36 | 160 | 159 | |
| Blood group | A Pos | A Pos | O Pos | B Pos | O Pos |
Discussion: Systemic loxoscelism from Loxosceles reclusa in USA is associated with a high incidence of severe hemolytic anemia. Increased awareness of the delayed presentation with hemolysis after initial signs of systemic loxoscelism could avoid life threatening events. Initial symptoms developed within 48 hours of the spider bite and led to medical attention in all of the reported cases.
With appropriate follow up, peripheral smear review and labs at 5-7 days after the spider bite most of the cases would have been recognized early and could have potentially avoided life threatening complications.
The different species of Loxosceles prevalent in South America could explain the difference in the incidence of hemolytic anemia. Studies from Brazil have reported the use of antivenom in about 50% of loxoscelism cases. Effectiveness of antivenom is not established and is seldom used in the USA but, could account for some differences in the incidence of hemolysis.
No relevant conflicts of interest to declare.
Author notes
Asterisk with author names denotes non-ASH members.